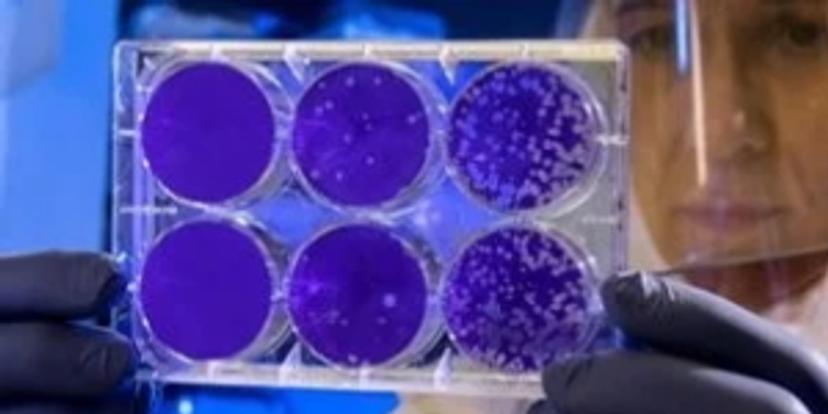

9 top resources for your COVID-19 & infectious disease research
Exclusive interviews, new methods, free downloads, and much more to help you advance your work
3 Aug 2020

In the current coronavirus pandemic, scientific discovery has evolved rapidly, making it more important than ever to effectively disseminate information about the biology of the virus, new methods of detection and diagnosis, as well as means of prevention and therapy of future infectious diseases. Scientific progress depends on the efficient transmission of research results to the scientific community, enabling discoveries to be assessed and extended. In this compilation of top resources, we hear from leading scientists about the latest in infectious disease diagnostics, from improved point-of-care testing and virus detection to new tools and techniques for COVID-19 research.

Genetic mapping: COVID-19: A new guest in the city-biome
Dr. Christopher Mason, Associate Professor at Weill Cornell Medical College, discusses the impact of COVID-19 on his work on genetic mapping, and shares how lab automation solutions available from Tecan have assisted his SARS-CoV-2 research.

Human primary cells: Specialty cell culture tools for COVID-19 research
Find out more about the cell culture portfolio from PromoCell, including well-characterized and standardized human primary airway epithelial cells for SARS-CoV-2 infection studies.

RT-qPCR: Detect SARS-CoV-2 viral strains with high sensitivity
Find out how the RapiDxFire™ 1-Step RT-qPCR System from LGC Biosearch Technologies can detect with a sensitive LoD, high reproducibility, and robust stability for US CDC’s 2019-nCoV signatures, including N1 and N2.
Point-of-care: Fast, sensitive, and cost-effective virus detection
Learn how customized screen-printed electrodes (SPEs) from Metrohm Dropsens allow for rapid point-of-care testing for a range of viruses, at low costs and various configurations.

Broad-range PCR: 16S/18S broad-range PCR for culture-negative infections
Discover the added clinical value of broad-range 16S/18S rDNA PCR from Molzym, along with sequencing analysis of culture-negative samples, and see how this impacts antimicrobial therapy selection.

Flow imaging microscopy: Reveal particles missed by DLS and NTA
Find out how the FlowCam 8000 from Yokogawa Fluid Imaging Technologies overcomes the challenges of traditional particle analysis methods by detecting micron-sized impurities and protein aggregates.

Food safety: SARS-CoV-2 testing for food packaging and the environment
Discover a new testing workflow from Thermo Fisher Scientific designed to detect SARS-COV-2 from food packaging and the environment to decrease potential contamination and subsequent infection.

Bridging assay: New and improved detection of COVID-19 antibodies
Find out more about the new bridging assay developed by LGC that detects COVID-19 in just 2 hours, increases result certainty, and is compatible with home sampling devices.

SARS-CoV-2 spike: New therapeutic target to combat COVID-19
Find out more about the potentially druggable pocket within the SARS-CoV-2 Spike glycoprotein and its role in the development of new COVID-19 treatment, in this webinar from Genscript.
More exclusive interviews:
- Validation of anti-COVID-19 drugs using the diagnostic tools of the future: Prof. Antonio D'Avolio explains how LC-MS technology is being used to quantify the experimental drug remdesivir. Read article>>
- Scientists crack bacteria quantification challenge in quest for novel infection therapies: Dr. Dennis Nurjadi discusses the cell counting technology that has brought his team accuracy and reproducibility. Read article>>
Other resources:
- Cell imaging technology eBook: Explore the key factors to consider when purchasing your cell imager, covering the range of applications from basic cell counts and confluence to automated cell-based assays and 3D cell culture. Download Guide>>
- Immunoassay analyzers eBook: Discover important information on the different types of immunoassay technology, automation options, disease state assays, and other considerations when choosing an analyzer for your lab. Download eBook>>
- Monitor viral cytopathic effects in real-time: ACEA Biosciences shares why the rapid and high-throughput xCELLigence Real-Time Cell Analysis workflow is ideal for infectious viral assays. Download Guide>>
Your recommendations:
Take a look at what other researchers and scientists all over the world are saying about the latest equipment and technologies being used in coronavirus research. Nikita Delgaty, biomedical scientist at SYNLAB UK & Ireland, shared her opinion of theRAPIDPoint 500e Blood Gas System from Siemens Healthineers:

Find more news and resources in our COVID-19 & Infectious Disease Special Feature>>





